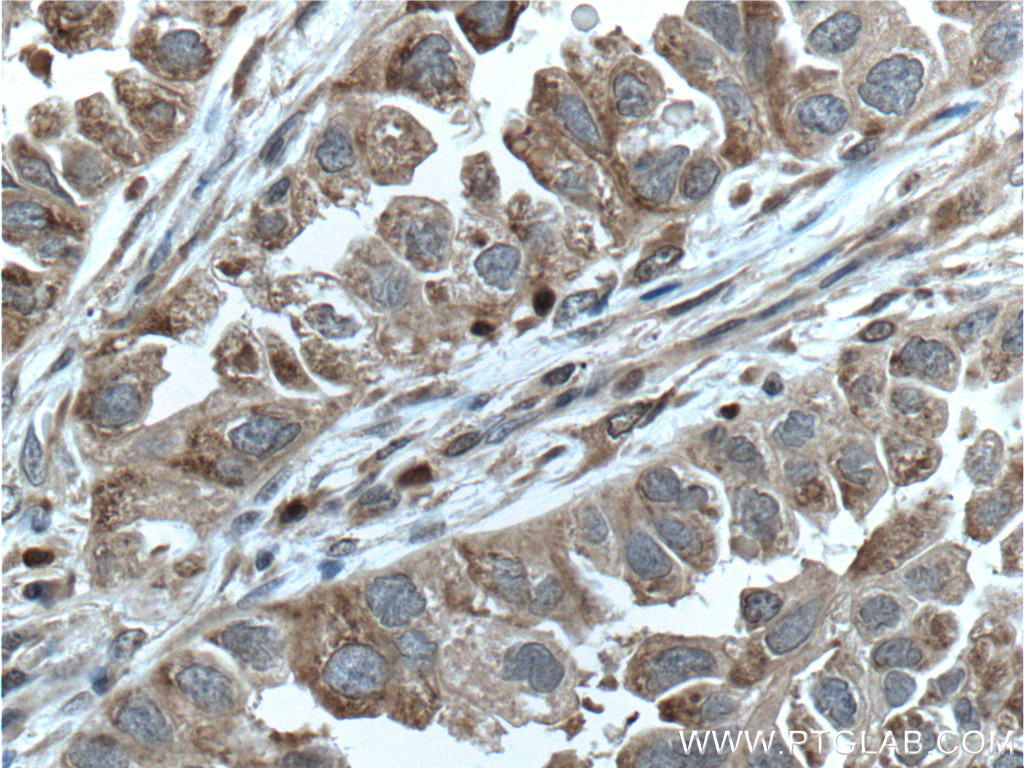

验证数据展示
经过测试的应用
| Positive WB detected in | HeLa cells, PC-3 cells, PC3 cells, U251 cells, U87-MG cells |
| Positive IHC detected in | human lung cancer tissue, human normal colon Note: suggested antigen retrieval with TE buffer pH 9.0; (*) Alternatively, antigen retrieval may be performed with citrate buffer pH 6.0 |
| Positive IF/ICC detected in | PC-3 cells |
推荐稀释比
| 应用 | 推荐稀释比 |
|---|---|
| Western Blot (WB) | WB : 1:500-1:2000 |
| Immunohistochemistry (IHC) | IHC : 1:100-1:400 |
| Immunofluorescence (IF)/ICC | IF/ICC : 1:50-1:500 |
| It is recommended that this reagent should be titrated in each testing system to obtain optimal results. | |
| Sample-dependent, Check data in validation data gallery. | |
产品信息
15171-1-AP targets GPI in WB, IHC, IF/ICC, ELISA applications and shows reactivity with human, mouse, rat samples.
| 经测试应用 | WB, IHC, IF/ICC, ELISA Application Description |
| 文献引用应用 | WB, IHC, IF |
| 经测试反应性 | human, mouse, rat |
| 文献引用反应性 | human, mouse, rat, pig |
| 免疫原 |
CatNo: Ag7423 Product name: Recombinant human GPI protein Source: e coli.-derived, PGEX-4T Tag: GST Domain: 1-272 aa of BC004982 Sequence: MAALTRDPQFQKLQQWYREHRSELNLRRLFDANKDRFNHFSLTLNTNHGHILVDYSKNLVTEDVMRMLVDLAKSRGVEAARERMFNGEKINYTEGRAVLHVALRNRSNTPILVDGKDVMPEVNKVLDKMKSFCQRVRSGDWKGYTGKTITDVINIGIGGSDLGPLMVTEALKPYSSGGPRVWYVSNIDGTHIAKTLAQLNPESSLFIIASKTFTTQETITNAETAKEWFLQAAKDPSAVAKHFVALSTNTTKVKEFGIDPQNMFEFWDWVGG 种属同源性预测 |
| 宿主/亚型 | Rabbit / IgG |
| 抗体类别 | Polyclonal |
| 产品类型 | Antibody |
| 全称 | glucose phosphate isomerase |
| 别名 | AMF, EC:5.3.1.9, Glucose-6-phosphate isomerase, GNPI, Neuroleukin |
| 计算分子量 | 63 kDa |
| 观测分子量 | 55-64 kDa |
| GenBank蛋白编号 | BC004982 |
| 基因名称 | GPI |
| Gene ID (NCBI) | 2821 |
| RRID | AB_2263537 |
| 偶联类型 | Unconjugated |
| 形式 | Liquid |
| 纯化方式 | Antigen affinity purification |
| UNIPROT ID | P06744 |
| 储存缓冲液 | PBS with 0.02% sodium azide and 50% glycerol, pH 7.3. |
| 储存条件 | Store at -20°C. Stable for one year after shipment. Aliquoting is unnecessary for -20oC storage. |
背景介绍
GPI(Glucose-6-phosphate isomerase), which is also named as autocrine motility factor (AMF), phosphoglucose isomerase(PGI), Neuroleukinis(NLK), phosphohexose isomerase(PHI) or sperm antigen 36(SA-36), is a housekeeping cytosolic enzyme that plays a key role in both glycolysis and gluconeogenesis pathways. It is also a multifunctional protein that displays cytokine properties, eliciting mitogenic, motogenic, and differentiation activities, and has been implicated in tumor progression and metastasis (PMID:12783864, 19603112). This protein can exsit as a homodimer in the catalytically active form and a monomer in the secreted form (PMID:11371164). It has 2 isoforms produced by alternative splicing with the calculated molecular mass of 63-64kDa, and an apparent molecular mass of 55 and 64 kDa under non-reducing and reducing conditions, respectively(PMID: 19603112, 11004567).
实验方案
| Product Specific Protocols | |
|---|---|
| IF protocol for GPI antibody 15171-1-AP | Download protocol |
| IHC protocol for GPI antibody 15171-1-AP | Download protocol |
| WB protocol for GPI antibody 15171-1-AP | Download protocol |
| Standard Protocols | |
|---|---|
| Click here to view our Standard Protocols |
发表文章
| Species | Application | Title |
|---|---|---|
Cell Res Mannose antagonizes GSDME-mediated pyroptosis through AMPK activated by metabolite GlcNAc-6P | ||
Cell Res cMyc-mediated activation of serine biosynthesis pathway is critical for cancer progression under nutrient deprivation conditions. | ||
EMBO J Fatty acid synthesis is critical for stem cell pluripotency via promoting mitochondrial fission. | ||
EMBO Rep OMA1 reprograms metabolism under hypoxia to promote colorectal cancer development. |